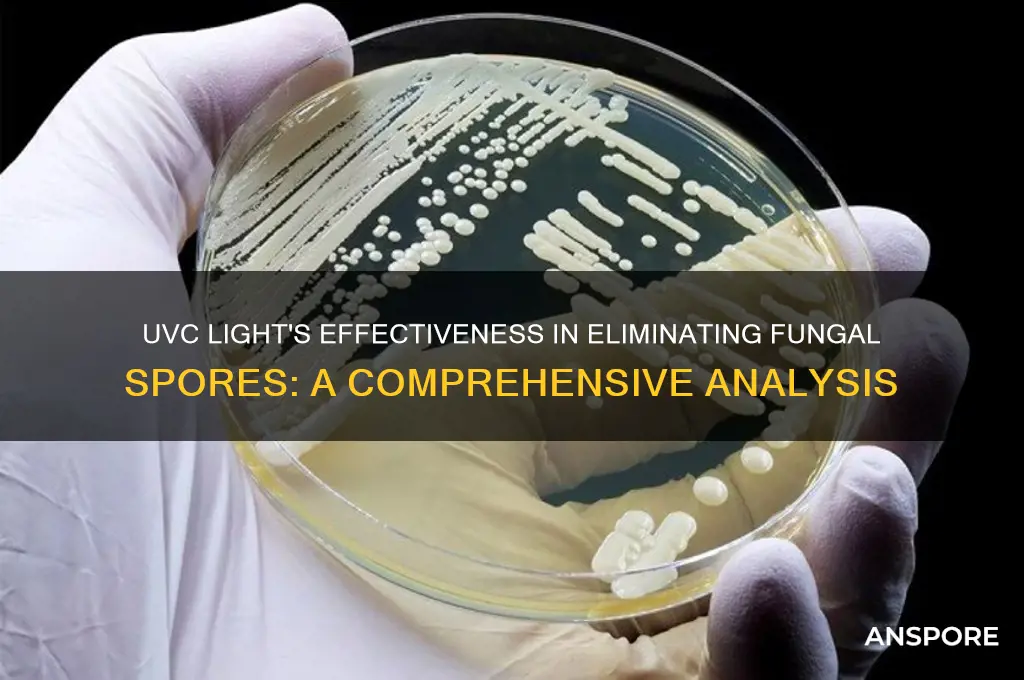
does uvc kill fungal spores

UV-C light, a short-wavelength ultraviolet light, is widely recognized for its germicidal properties, effectively inactivating bacteria, viruses, and certain types of fungi. However, its efficacy against fungal spores, which are notoriously resilient due to their thick cell walls, remains a topic of interest and ongoing research. While UV-C light has been shown to damage the DNA of fungal spores, reducing their viability, the extent of its effectiveness can vary depending on factors such as the species of fungus, the intensity and duration of UV-C exposure, and the environmental conditions. Understanding whether UV-C can reliably kill fungal spores is crucial for applications in healthcare, food safety, and environmental disinfection, where fungal contamination poses significant challenges.
| Characteristics | Values |
|---|---|
| Effectiveness on Fungal Spores | UVC light can inactivate fungal spores, but effectiveness varies by species and exposure conditions. |
| Wavelength Range | 200–280 nm (peak effectiveness around 254 nm). |
| Mechanism of Action | Damages DNA and RNA, preventing replication and cell function. |
| Required Exposure Time | Typically 1–10 minutes, depending on spore type and UVC intensity. |
| Factors Affecting Efficacy | Spore thickness, UVC dose, distance from light source, and environmental conditions (e.g., humidity, temperature). |
| Common Fungal Spores Affected | Aspergillus, Penicillium, Cladosporium, and others, with varying susceptibility. |
| Limitations | Less effective on thicker spores or those protected by organic matter. |
| Applications | Used in air purification, surface disinfection, and water treatment to control fungal contamination. |
| Safety Concerns | UVC exposure is harmful to humans and animals; requires proper shielding and controlled use. |
| Complementary Methods | Often used alongside other disinfection methods (e.g., chemical agents, filtration) for comprehensive control. |
Explore related products
What You'll Learn

UVC Wavelength Effectiveness on Fungal Spores
Ultraviolet-C (UVC) light, specifically at 254 nm, is known to disrupt the DNA and RNA of microorganisms, rendering them incapable of reproduction. However, its effectiveness on fungal spores varies significantly depending on the species and exposure conditions. For instance, *Aspergillus niger* spores require a UVC dose of approximately 10–20 mJ/cm² for 90% inactivation, while *Cladosporium sphaerospermum* spores may need up to 50 mJ/cm² due to their thicker cell walls. This highlights the importance of tailoring UVC treatment to the specific fungal target.
To maximize UVC effectiveness on fungal spores, consider both dosage and exposure time. A study in *Journal of Applied Microbiology* found that shorter wavelengths (222 nm) can be more efficient, as they penetrate spore walls more effectively while minimizing damage to surrounding materials. However, this wavelength is less commonly available in commercial devices. For practical applications, ensure the UVC source is positioned optimally to deliver uniform irradiation, and calculate the required exposure time based on the spore type and desired inactivation rate.
While UVC is a powerful tool, its limitations must be acknowledged. Fungal spores are notoriously resilient, and some species, like *Cryptococcus neoformans*, exhibit higher resistance due to melanin pigmentation, which absorbs UVC light. Additionally, environmental factors such as humidity and surface material can reduce UVC penetration. For example, spores on porous surfaces may require higher doses compared to those on smooth, non-porous materials. Combining UVC with other methods, such as chemical disinfectants or physical removal, can enhance overall efficacy.
In real-world applications, UVC is increasingly used in HVAC systems, food processing, and healthcare settings to control fungal contamination. For instance, in hospitals, UVC lamps installed in ventilation systems can reduce airborne spore counts by up to 99% when operated at 10–15 mJ/cm² for 30 minutes daily. However, safety precautions are critical, as UVC exposure can harm human skin and eyes. Always use automated systems or ensure areas are unoccupied during treatment. Regularly monitor UVC output, as bulb degradation over time can reduce effectiveness.
For home users, portable UVC devices offer a practical solution for surface disinfection. When targeting fungal spores on household items, maintain a distance of 15–20 cm from the surface and expose for 5–10 minutes, depending on the device’s intensity. Avoid using UVC on heat-sensitive materials, as prolonged exposure can cause damage. While UVC is not a standalone solution for fungal control, its strategic application can significantly reduce spore viability, contributing to healthier environments.
Mold Spores: Unveiling Their Role as Reproductive Structures
You may want to see also

Fungal Spore Resistance to UVC Radiation
UVC radiation, typically emitted at wavelengths between 200 and 280 nanometers, is widely recognized for its germicidal properties, effectively inactivating bacteria, viruses, and some fungi. However, fungal spores present a unique challenge due to their inherent resistance mechanisms. Unlike vegetative fungal cells, spores possess thick cell walls composed of chitin and melanin, which act as natural barriers against UVC penetration. Studies show that while UVC can damage fungal DNA, the protective layers of spores often require significantly higher doses—up to 10 times more than those needed for bacterial inactivation—to achieve similar results. This disparity highlights the need for tailored UVC applications when targeting fungal spores in environments like hospitals, food processing facilities, or HVAC systems.
To effectively combat fungal spores with UVC, understanding dosage and exposure time is critical. Research indicates that a minimum UVC dose of 10–20 mJ/cm² is often required to achieve a 90% reduction in fungal spore viability, depending on the species. For example, *Aspergillus niger* spores, commonly found in indoor environments, exhibit higher resistance compared to *Penicillium* species. Practical applications should consider using UVC lamps with output intensities of at least 30 mW/cm² and ensuring exposure times of 30–60 seconds for optimal results. Additionally, combining UVC with other disinfection methods, such as HEPA filtration or chemical agents, can enhance efficacy, particularly in high-risk settings.
Despite its potential, UVC’s effectiveness against fungal spores is not universal. Factors like spore age, humidity, and surface material can influence resistance. Younger spores, for instance, are more susceptible to UVC than mature ones due to differences in cell wall thickness. Humidity levels above 60% can also reduce UVC efficacy by scattering radiation, while porous surfaces may shield spores from direct exposure. To mitigate these challenges, maintain relative humidity below 50% during UVC treatment and ensure surfaces are clean and non-porous for maximum contact. Regular monitoring of UVC lamp intensity, using radiometers, is essential to confirm consistent performance over time.
From a comparative perspective, fungal spores’ resistance to UVC contrasts sharply with their vulnerability to heat and desiccation. While UVC targets nucleic acids, heat treatment at 60–80°C for 30 minutes can effectively kill spores by denaturing proteins. However, UVC remains a preferred method in sensitive environments where heat or chemicals are impractical. For instance, in museums or archives, UVC can disinfect air and surfaces without damaging artifacts. By acknowledging the limitations and optimizing UVC parameters, practitioners can harness its benefits while addressing fungal spore resistance strategically.
Purple Spore Prints: Are Any Poisonous Mushrooms Hiding in This Hue?
You may want to see also

Optimal UVC Dosage for Spore Inactivation
UVC light's effectiveness against fungal spores hinges on precise dosage. Unlike bacteria, fungal spores possess robust cell walls, demanding higher UVC energy to achieve inactivation. This energy is measured in millijoules per square centimeter (mJ/cm²), and finding the optimal dosage is crucial for successful spore eradication.
Studies reveal a spectrum of susceptibility among fungal species. For instance, *Aspergillus niger* spores may require upwards of 200 mJ/cm² for complete inactivation, while *Penicillium* species might succumb to doses as low as 50 mJ/cm². This variability underscores the need for species-specific dosage guidelines.
Determining the optimal UVC dosage involves a delicate balance. Insufficient exposure allows spores to survive, while excessive doses can damage surrounding materials or pose safety risks. Factors like spore concentration, UVC wavelength (peak efficacy around 254 nm), and exposure time all influence the required dosage.
A practical approach involves gradual escalation. Start with a conservative dose based on the suspected fungal species, then incrementally increase exposure time or intensity until complete inactivation is confirmed through laboratory testing. This iterative process ensures both efficacy and safety.
Real-world applications demand careful consideration. In healthcare settings, UVC disinfection of surfaces contaminated with fungal spores requires precise control to avoid harming equipment or personnel. Similarly, in food processing, UVC treatment of packaging materials must balance spore inactivation with preserving product quality.
Ultimately, achieving optimal UVC dosage for spore inactivation requires a nuanced understanding of fungal biology, UVC technology, and application-specific constraints. By tailoring dosage to the target species and context, UVC light emerges as a powerful tool for combating fungal contamination in diverse settings.
Can You Beat Spore? Mastering the Game's Ultimate Challenges
You may want to see also
Explore related products

UVC vs. Common Fungal Species Survival
UVC light, with its wavelength range of 200 to 280 nanometers, is a potent tool against microbial life, but its effectiveness against fungal spores varies significantly across species. For instance, *Aspergillus niger*, a common mold found in indoor environments, exhibits moderate resistance to UVC, requiring doses of at least 10 mJ/cm² to achieve a 90% reduction in spore viability. In contrast, *Cladosporium sphaerospermum*, another widespread mold, is more susceptible, with spores inactivated by doses as low as 5 mJ/cm². These differences underscore the importance of tailoring UVC treatment protocols to the specific fungal species present.
To maximize UVC’s efficacy against fungal spores, consider the following practical steps. First, identify the fungal species through laboratory testing or environmental sampling, as this informs the required dosage. Second, ensure UVC lamps emit within the optimal germicidal range (254 nm) and are positioned to deliver uniform exposure. Third, account for environmental factors like humidity and surface material, as organic matter can shield spores from UVC radiation. For example, spores embedded in dust or on porous surfaces may require higher doses or longer exposure times.
A comparative analysis reveals that UVC’s effectiveness against fungal spores is not solely determined by dosage but also by spore structure. *Cryptococcus neoformans*, a pathogenic yeast, possesses a thick capsule that confers resistance to UVC, necessitating doses exceeding 20 mJ/cm² for significant inactivation. Conversely, *Penicillium chrysogenum* spores, with their thinner cell walls, are more vulnerable, succumbing to doses around 8 mJ/cm². This highlights the need for species-specific approaches in UVC applications, particularly in healthcare and food processing settings where fungal contamination poses risks.
Persuasively, integrating UVC technology into fungal control strategies offers a chemical-free, environmentally friendly alternative to traditional fungicides. However, its limitations must be acknowledged. UVC’s inability to penetrate opaque materials or reach shadowed areas means it should complement, not replace, other disinfection methods. For instance, combining UVC with HEPA filtration systems in HVAC units can reduce airborne fungal spores, while periodic physical cleaning ensures surfaces are free of organic debris that might protect spores.
In conclusion, UVC’s role in combating fungal spores is both promising and nuanced. By understanding the survival mechanisms of common fungal species and optimizing UVC application parameters, users can harness its potential effectively. Whether in hospitals, food storage facilities, or homes, a tailored approach ensures UVC remains a valuable tool in the fight against fungal contamination.
Does Meiosis Occur in Fungi Spores? Exploring Fungal Reproduction
You may want to see also

Practical Applications of UVC in Fungal Control
UVC light, with its wavelength range of 200 to 280 nanometers, has been proven effective in inactivating various microorganisms, including certain fungal spores. This capability opens up a range of practical applications in fungal control across different industries. For instance, in healthcare settings, UVC can be used to disinfect surfaces and equipment, reducing the risk of fungal infections such as aspergillosis and candidiasis. A typical UVC dosage of 10-20 mJ/cm² is sufficient to achieve a 99.9% reduction in fungal spore viability, making it a valuable tool in infection prevention protocols.
In the agricultural sector, UVC offers a chemical-free alternative for controlling fungal pathogens that affect crops. By installing UVC lamps in greenhouses or using portable devices in fields, farmers can target spores of fungi like Botrytis cinerea and Fusarium, which cause significant yield losses. The key is to apply UVC during the early stages of fungal development, as mature spores may require higher dosages (up to 30 mJ/cm²) for effective inactivation. This method not only reduces reliance on fungicides but also minimizes environmental impact.
For home use, UVC devices are increasingly being adopted to combat mold and mildew in damp areas like bathrooms and basements. Handheld UVC wands or small room sanitizers can be used to treat surfaces where fungal spores thrive. However, caution is essential; direct exposure to UVC light can harm human skin and eyes, so these devices should be operated in unoccupied spaces. A 5-10 minute treatment with a UVC intensity of 1-2 mW/cm² is generally effective for surface-level fungal control in residential settings.
Comparatively, UVC’s application in HVAC systems highlights its versatility in fungal management. By integrating UVC lamps into air ducts, spores circulating through the system can be neutralized, improving indoor air quality and reducing allergy symptoms. This approach is particularly beneficial in buildings with high humidity levels, where fungal growth is more prevalent. Maintenance is critical here; lamps should be replaced every 9,000 hours to ensure consistent efficacy, as UVC output diminishes over time.
Finally, the food industry leverages UVC for fungal control during processing and packaging. Conveyor systems equipped with UVC lamps can treat fruits, vegetables, and grains, extending shelf life by eliminating surface spores. For example, a UVC dose of 15 mJ/cm² can effectively reduce Penicillium spores on apples without affecting taste or texture. This non-thermal method preserves nutritional value while ensuring food safety, making it an attractive option for producers aiming to meet stringent quality standards.
Can Spores Get Contaminated? Understanding Risks and Prevention Methods
You may want to see also
Frequently asked questions
Yes, UVC light is effective at killing fungal spores by damaging their DNA and RNA, preventing them from reproducing and causing infections.
The most effective wavelength of UVC light for killing fungal spores is around 254 nanometers (nm), as it is highly germicidal and targets the nucleic acids of microorganisms.
The required exposure time varies depending on the type of fungal spore and the intensity of the UVC light, but typically ranges from a few seconds to several minutes for effective disinfection.
While UVC light is highly effective, its ability to eliminate fungal spores depends on factors like surface material, distance from the light source, and shadowing. It works best in controlled environments with direct exposure.





























